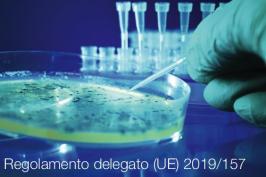
Regolamento delegato (UE) 2019/157

Decreto 15 febbraio 2019 | Suppl. 9.6 Farmacopea europea 9ª ed.

Decreto 15 febbraio 2019 | Suppl. 9.6 Farmacopea europea 9ª ed.
Decreto 15 Febbraio 2019
Entrata in vigore dei testi, nelle lingue inglese e francese, pubblicati nel Supplemento 9.6 della Farmacopea…
Leggi tutto Decreto 15 febbraio 2019 | Suppl. 9.6 Farmacopea europea 9ª ed.Vacuum-Jacketed Piping in Liquid Oxygen Service

Vacuum-Jacketed Piping in Liquid Oxygen Service
EIGA Doc. 217/19
In recent years, the increase in the size and production capacity of air separation plants has led to a corresponding increase in the…
Leggi tutto Vacuum-Jacketed Piping in Liquid Oxygen ServiceREACH Authorisation Decisions List: Last update 28.02.2019

REACH Authorisation Decisions List
REACH Authorisation Decisions List of authorisation decisions adopted on the basis of Article 64 of Regulation (EC) No 1907/2006 (REACH). The list also includes reference to related documentation…
Leggi tutto REACH Authorisation Decisions List: Last update 28.02.2019Decreto 21 dicembre 2018
Decreto 21 dicembre 2018
Aggiornamento dell'allegato 13 al decreto 29 aprile 2010, n. 75, recante: «Riordino e revisione della disciplina in materia di fertilizzanti, a norma dell'articolo 13 della legge 7…
Leggi tutto Decreto 21 dicembre 2018Miscele chimiche: esposizione combinata dell’uomo EFSA
Miscele chimiche: esposizione combinata dell’uomo EFSA
Introduzione
Le persone, gli animali e l'ambiente possono essere esposti a più sostanze chimiche tramite una molteplicità di fonti. L'EFSA ha già sviluppato alcuni approcci…
Leggi tutto Miscele chimiche: esposizione combinata dell’uomo EFSARegolamento delegato (UE) 2019/157
Regolamento delegato (UE) 2019/157
Regolamento delegato (UE) 2019/157 della Commissione del 6 novembre 2018 che modifica l'allegato II del regolamento delegato (UE) n. 1062/2014relativo al programma di lavoro per l'esame sistematico di tutti i principi…
Leggi tutto Regolamento delegato (UE) 2019/157Decreto 15 febbraio 2019 | Suppl. 9.5 Farmacopea europea 9ª ed.

Decreto 15 febbraio 2019 | Suppl. 9.5 Farmacopea europea 9ª ed.
Decreto 15 Febbraio
Entrata in vigore dei testi, nelle lingue inglese e francese, pubblicati nel Supplemento 9.5 della…
Leggi tutto Decreto 15 febbraio 2019 | Suppl. 9.5 Farmacopea europea 9ª ed.Rischio industriale: elenco stabilimenti Seveso III - Dicembre 2018

Rischio industriale: nuovo elenco degli stabilimenti soggetti al D.lgs. 105/2015
Aggiornamento: 31 Dicembre 2018
Predisposto dalla Direzione Generale per le Valutazioni e Autorizzazioni Ambientali - Divisione III - Rischio rilevante e autorizzazione…
Leggi tutto Rischio industriale: elenco stabilimenti Seveso III - Dicembre 2018Regolamento delegato (UE) 2019/330
Regolamento delegato (UE) 2019/330
Regolamento delegato (UE) 2019/330 della Commissione dell'11 dicembre 2018 che modifica gli allegati I e V del regolamento (UE) n. 649/2012del Parlamento europeo e del Consiglio sull'esportazione e importazione di…
Leggi tutto Regolamento delegato (UE) 2019/330Five cobalt salts proposed for restriction - ECHA

Five cobalt salts proposed for restriction
Update 21.02.2019
In response to a request by the European Commission, ECHA submitted a restriction dossier in October 2018 concerning five cobalt salts.…
ECHA: "no deal" scenario ahead of the UK’s withdrawal on 30 March 2019

Act now to stay on the EU market after the UK’s withdrawal
Helsinki, 8 February 2019 - ECHA recommends companies to prepare for a ‘no deal’ scenario ahead of the UK’s…
Leggi tutto ECHA: "no deal" scenario ahead of the UK’s withdrawal on 30 March 2019Substances in articles Art. 33 of REACH | Orgalime

Communication obligations on substances in articles Article 33 of Regulation (EC) No 1907/2006 | Information Note
Article 33 of Regulation (EC) No 1907/2006 of the European Parliament and of the Council on…
Leggi tutto Substances in articles Art. 33 of REACH | OrgalimeAltri articoli...
- Raccomandazioni agli operatori | Min. Salute
- Piano Emergenza Esterno Centrale Nucleare di Caorso
- Relazione speciale n. 02/2019: Pericoli chimici negli alimenti
- REACH Authorisation Decisions List: Last update 14.01.2019
- ECHA: Update Candidate list 15.01.2019
- Vigilanza e controllo alimenti e bevande Anno 2017
- Regolamento (UE) 2019/37
- Safety in storage, handling and distribution of liquid hydrogen
- Comunicazione 2018/C 239/03
- ICQRF - Ispettorato antifrodi alimentari











































